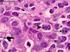
DIFFUSE LARGE B-CELL LYMPHOMA

1. Introduction. 2. Clinical aspects
|
|
|
- Walter Hoover
- 9 years ago
- Views:
Transcription
1 1. Introduction MabThera (rituximab) is a genetically engineered chimeric mouse/human monoclonal antibody which binds specifically to the transmembrane antigen, CD20. This antigen is located on pre-b- and mature B-lymphocytes, but not on hemopoietic stem cells, pro-b cells, normal plasma cells or other normal cells. The CD20 antigen is also expressed on >95% of all B cell NHL. After binding to the CD20 antigen on the cell surface, rituximab is believed to exert its therapeutic effect by promoting B cell lysis. Possible mechanisms of cell lysis include complement-dependent cytotoxicity, antibodydependent cellular cytotoxicity and induction of apoptosis. MabThera is available in single-use vials containing 100 mg/10 ml and 500 mg/50 ml concentrate for solution for infusion. It is currently indicated for the treatment of patients with follicular lymphoma stage III-IV who are chemoresistant or are in their second or subsequent relapse after chemotherapy, for the treatment of previously untreated patients with stage III-IV follicular lymphoma in combination with CVP chemotherapy, and for the treatment of patients with CD20 positive diffuse large B cell non-hodgkin s lymphoma (NHL) in combination with CHOP chemotherapy. The Marketing Authorisation Holder, Roche, applied for the extension of the indication in maintenance treatment of patients with follicular lymphoma responding to induction therapy. The application is based on a randomized, open-label, inter-group, multi-center, prospective, controlled clinical trial with 334 patients (study EORTC 20981) comparing maintenance treatment with 375mg/m² i.v. once every 3 months for up to 24 months with observation in the treatment of follicular lymphoma. 2. Clinical aspects Follicular lymphoma, the second most common subtype of NHL, is an illness of middle-aged and older people, with a median age at diagnosis of approximately 60 years. Most patients (>80%) with follicular lymphoma present with widespread disease at the time of diagnosis. Although the disease generally follows an indolent course, with a median survival of 8-10 years from diagnosis, it is considered to be incurable with currently available treatments. Therefore, treatment initiation is usually delayed until the disease becomes symptomatic and requires therapeutic intervention. Once treatment is warranted, initial response rates are typically high, but are followed inevitably by relapse. Subsequent treatments after relapse still achieve remissions, but at progressively lower rates and of shorter durations. Over the course of the disease, a patient with follicular lymphoma usually receives between 3 and 7 different treatment regimens of varying intensities. Standard treatment consists of single or multidrug chemotherapy, which is today usually combined with anti-cd20 antibodies. The problem is obtaining durable remissions. Maintenance treatment to prolong the duration of remission has been attempted with cytotoxic agents or interferon-alpha, and trials have suggested some benefit. However, short and long term toxicity as well as inconvenience has limited the adoption into clinical practice, and other less toxic alternatives are sought. The likelihood of developing resistant lymphoma or secondary malignancies (e.g. myelodysplastic syndrome [MDS] or acute myeloid leukemia [AML]) increases with time and the number, intensity and choice of previous cytotoxic treatments. Five-year incidence rates of approximately 3% to 18% have been reported for MDS/AML after high-dose chemotherapy with stem cell support for follicular lymphoma and the prognosis is poor. Follicular lymphoma may also transform to an intermediate or high-grade lymphoma. This occurs in 40% to 70% of patients by 8-10 years after diagnosis. Once transformation has occurred, the prognosis is generally poor, with a median survival of between 2.5 and 22 months. The majority of patients with follicular lymphoma eventually die from their disease. 1
2 The addition of rituximab to standard induction chemotherapy in indolent lymphomas has been shown to improve outcome. Hence, the possibility that rituximab as maintenance treatment might prolong remission duration was investigated. Rituximab is being developed for the treatment of CD20 positive lymphomas, and recently also for certain autoimmune diseases, e.g. rheumatoid arthritis. Rituximab is already approved, either alone or in combination with chemotherapy, as induction treatment for patients with follicular lymphoma or diffuse large B cell lymphoma. The clinical development program for rituximab as maintenance treatment for patients with follicular lymphoma responding to induction therapy consists mainly of data from one large pivotal study phase III study (EORTC 20981) including 334 patients randomized in the maintenance phase. Supportive data on the use of rituximab in the maintenance setting are provided from five studies (GLSG-FCM, SAKK 35/98, LYM-5, U0824n, ECOG 1496). A large proportion of patients with follicular lymphoma are elderly, and analyses of toxicity in this subgroup were specifically carried out. Follicular lymphoma is extremely rare in children, and no particular paediatric development was made Pharmacokinetics No new pharmacokinetic data have been submitted. The standard rituximab dose of 375 mg/m2 was used in both parts of study EORTC This dose has been shown to be effective in previous studies in follicular lymphoma as well as in other indications, and is therefore the recommended dose for maintenance treatment in follicular lymphoma. A pharmacokinetic study in patients with relapsed/recurrent NHL (Bernstein et al., Ann. Oncol., 1998) showed that at 3 month responders had a higher median rituximab serum levels 25.4 µg/ml compared to 5.9 µg/ml in non-responders. The majority of patients (104/143) had detectable rituximab levels at 3 months whereas only 13/104 had detectable rituximab levels at 6 months. A second study in patients with B-cell lymphoproliferative disorders (Gordan et al., J. Clin. Oncol., 2005) indicated that rituximab should be administered every 2-4 months to maintain drug levels above 25 µg/ml. These studies support a 3-monthly dosing schedule for rituximab for maintenance treatment Clinical efficacy National Scientific Advice was given by the DKMA, Denmark, (rapporteur), October 2004, and by the AFSSAPS, France, January 2005, regarding the length of follow-up and the necessity for analyses of patient subgroups according to induction regimen. The advice was followed. The pivotal study (EORTC 20981) was conducted according to the EU GCP guidelines and in agreement with the Declaration of Helsinki (as amended in Tokyo, Venice and Hong Kong). The protocol, the protocol amendments, the patient information sheet, informed consent, and the case report form (CRF) were approved by the EORTC Protocol Review Committee and by the local, regional or national Ethical Review Boards. All studies in the rituximab clinical development program were performed in accordance with current standards for the design, conduct, and analysis of clinical research. Clinical Trials One large randomized study (EORTC 20981) including 334 patients was submitted as the main study supporting the claimed indication. In addition to the pivotal study EORTC 20981, supportive data from five published studies (GLSG-FCM, SAKK35/98, LYM-5, U0824n and ECOG 1496) of rituximab maintenance regimens are provided. Out of those, three studies (GLSG-FCM, SAKK35/98 and LYM-5) were performed in relapsed/refractory patients and two studies in previously untreated patients (ECOG 1496 and U0824n). Table 1 and 2 below provide an overview of submitted studies with rituximab maintenance in NHL. 2
3 Table 1 Overview of submitted studies in support of the indication maintenance treatment Induction regimen Relapsed or refractory indolent NHL Pivotal study EORTC CHOP vs. R- CHOP Study Type Total number of patients enrolled induction/maintenance Median follow-up time Randomized 465/334 31months induction 28months maintenance Randomized 147/ months GLSG-FCM FCM or R- (Hiddemann et al 1 ) FCM LYM-5 Rituximab Randomized 114/90 41 months (Hainsworth et al 2 )) Previously untreated indolent NHL U0824n Rituximab Nonrandomized 55 months (Hainsworth et al 3 ) ECOG 1496 N/A (Hochster et al 4 ) Both previously treated and untreated indolent NHL SAKK 35/98 (Ghielmini et Rituximab Randomized 202/ months al 5 ) Table 2: Submitted studies: Rituximab maintenance regimens Maintenance Active regimen Relapsed or refractory indolent NHL Pivotal study EORTC Rituximab 375 mg/m 2 every 3 months until disease progression or for a maximum period of two years GLSG-FCM Rituximab 375 mg/m 2 weekly for 4 weeks at 3 and 9 months after end of induction LYM-5 Standard regimen repeated at 6 monthly intervals for 4 courses or rituximab retreatment at relapse Previously untreated indolent NHL U0824n Non-randomized Maintenance control regimen observation 334 observation 184 None, in the control arm rituximab was given after relapse as retreatment 62 Standard regimen repeated at 6 monthly intervals for 4 courses ECOG 1496 Rituximab 375 mg/m 2 weekly for 4 Observation 322 weeks, repeated 6 monthly for 4 courses Both previously treated and untreated indolent NHL SAKK 35/98 Rituximab 375 mg/m 2 every 2 months for 4 courses observation 151 N (maint) 44 maintenance 46 retreatment 1 Hiddemann et al: Rituximab maintenance following a rituximab containing chemotherapy significantly prolongs the duration of response in patients with relapsed follicular and mantle cell lymphomas: Results of a prospective randomized trial of the German Low Grade Lymphoma Study Group (GLSG) ASCO 2005; abstract Hainsworth JD et al: Maximizing therapeutic benefit of rituximab: maintenance therapy with indolent non-hodgkin s lymphoma- a randomized phase II trial of the Minnie Pearl Cancer Research Network. J Clin Oncol ; 2005; 23 (6): Hainsworth JD et al: rituximab as first line and maintenance therapy for patients with indolent non Hodgkin s lymphoma J Clin Oncol 2002; 20 (20): Hochster et al: Results of E1496: A phase III trial of CVP with or without maintenance rituximab in advanced indolent lymphoma (NHL). Proc Am Soc Clin Oncol 2004; 23:: 556, abstract Ghielmini M et al: Prolonged treatment with rituximab in patients with follicular lymphoma significantly increases event-free survival and response duration compared with the standard weekly x 4 schedule. Blood 2004; 103 (12):
4 The tables above highlights the heterogeneity of submitted studies, in particular in terms of patients included (with relapsed disease or previously untreated) and dosing schedule of rituximab and duration of treatment. The pivotal study EORTC used a 3-monthly regimen of rituximab 375 mg/m2 until disease progression (or maximum of two years). Other supportive studies used different intervals of rituximab treatment. Pivotal study EORTC Primary objective To compare progression-free survival (PFS) (defined as the interval between the date of randomization to observation/maintenance and the date of first relapse, progression or death, which ever occurred first) in patients with relapsed or refractory follicular lymphoma treated with or without rituximab maintenance after achieving a complete or partial remission following induction therapy with either CHOP or R-CHOP. Secondary objective: The only protocol-specified secondary endpoint was overall survival. Exploratory endpoints, not specified in the study protocol but in the statistical analysis plan, were disease-free survival and time to new lymphoma treatment or death. Progression free survival is an adequate efficacy endpoint in indolent Non Hodgkin s lymphoma. However, progressive disease in follicular lymphoma may not always be accompanied by clinical symptoms. Efficacy Results Primary outcome: A significant benefit of rituximab maintenance treatment over observation was seen for the primary efficacy parameter, PFS, with the two curves beginning to separate after about 3 months (see Figure below). The Kaplan-Meier estimate of median time to progression was 14.3 months in the observation arm compared to 42.2 months in the rituximab maintenance arm (p < ; stratified [induction treatment and response] log-rank test). A higher proportion of patients in the observation arm (62%) compared to the rituximab arm (37%) had progressed at the time of the analysis. Few patients (3 observation vs. 5 maintenance) died prior to disease progression. Maintenance treatment with rituximab significantly reduced the risk of disease progression by 61% (95%CI: 45% to 72%) compared with observation. Kaplan-Meier Plot of Progression-Free Survival (Study EORTC 20981) Randomization in the maintenance phase was stratified by the type of induction regimen and quality of response to induction treatment. The benefits of maintenance treatment with rituximab over observation were seen regardless of the type of induction regimen (CHOP vs. R-CHOP) or the quality of response to induction therapy (CR vs. PR). 4
5 Rituximab maintenance significantly prolonged the median PFS for both patients responding to CHOP induction (11.6 months observation vs months rituximab, p<0.0001) and for patients responding to R-CHOP induction (22.1 months observation vs months rituximab, p=0.0071). The risk reduction for disease progression was more pronounced in patients who had received CHOP (71%, 95%CI 54% to 82%) compared to R-CHOP (46%, 95%CI 15% to 65%), probably due to the higher efficacy of R-CHOP as the induction regimen. Rituximab maintenance treatment also significantly prolonged the median PFS for patients with a CR (14.3 months observation vs months rituximab, p=0.0008) as well as for those with a PR (14.3 months observation vs months rituximab, p<0.0001). Amongst patients who achieved a CR following induction treatment, the risk reduction with rituximab maintenance treatment was 64% (95% CI: 33% to 81%) compared to 54% (95% CI: 33% to 69%) for those achieving a PR. This therefore emphasizes the need for an effective induction regimen to optimize the outcome with maintenance rituximab treatment. Progression-free Survival in Subgroups in the Maintenance Phase (Study EORTC 20981) Subgroup Median Time to Progression (months) Risk Reduction Observation Rituximab p value (95% Confidence Interval) (Log-Rank test) Overall population < % (45% to 72%) CHOP < % (54% to 82%) R-CHOP % (15% to 65%) CR % (33% to 81%) PR < % (33% to 69%) PFS was analyzed in subgroups defined by baseline prognostic factors. The benefit of maintenance treatment with rituximab over observation was seen in all subgroups except for the small subgroup of patients with bulky disease which was too small (19 observation, 18 rituximab) to allow for meaningful conclusions to be drawn. Progression-free Survival in Subgroups (Study EORTC 20981) Secondary outcome: The results from study EORTC showed a beneficial effect of rituximab maintenance treatment on overall survival compared with observation (p = , log-rank test). Although the median has not been reached in either study arm due to the small number of deaths (36 observation vs. 18 5
6 rituximab), rituximab maintenance treatment significantly reduced the risk of death by 56% (95% CI: 22% to 75%). Kaplan-Meier Plot of Overall Survival (Study EORTC 20981) The treatment effect with rituximab maintenance on overall survival in the CHOP vs. R-CHOP subgroups was significant and consistent with that seen in the overall population Due to the small number of deaths at the time of data-cut-off, longer follow-up is required before definitive conclusions can be drawn. Overall Survival in Subgroups in the Maintenance Phase (Study EORTC 20981) Population Risk Reduction (95% confidence Interval) p-value Log-rank test Overall population 56% (22% to 75%) CHOP 55% (4% to 79%) R-CHOP 56% (-2% to 81%) Improvements in the quality of response were observed in a small number of patients that were randomized to the maintenance phase. In the observation arm, 6 of 116 patients with a PR and one patient with no-change/stable disease at the start of the maintenance phase improved to a CR. In the rituximab arm, 13 of 114 patients with a PR at the start of maintenance improved to a CR and one patient with no-change/stable disease improved to a PR. Supportive studies Study GLSG-FCM This study investigated the impact of rituximab maintenance treatment on response duration after remission induction with either R-FCM or FCM chemotherapy in patients with relapsed or refractory follicular lymphoma (FL) and mantle cell lymphoma (MCL). Patients were first randomized to either 4 courses of chemotherapy with fludarabine (25 mg/m 2 /day on days 1-3), cyclophosphamide (200 mg/m 2 /day on days 1-3) and mitoxantrone (8 mg/m 2 on day 1) (FCM), or FCM plus rituximab (375 mg/m 2 on day 0). Patients achieving a complete or partial remission underwent a second randomization to either observation only or rituximab maintenance with 4 weekly doses of rituximab (375 mg/m 2 /day) three and nine months after the end of R-FCM/FCM induction therapy. Both randomizations were stratified by histology and preceeding therapy. The first randomization was stopped after 147 patients, when interim results demonstrated a significant improvement for R-FCM therapy for initial responses, progression free survival and overall survival. The study protocol was subsequently amended so that all patients would receive R-FCM induction treatment before the second randomization to rituximab maintenance therapy or observation only. 6
7 The study GLSG-FCM did include patients with mantle cell lymphomas (MCL) belonging to a different kind of subclass of NHL with a more dismal prognosis. Although innovative treatments (including rituximab) are acceptable for patients with MCL, the inclusion of patients with follicular lymphoma and MCL rendered the patient population more heterogeneous. Improvement was seen in both subtypes but was not yet statistically significant. Study SAKK 35/98 The objective of the multi-centre phase III trial SAKK35/98 was to compare the standard schedule of rituximab with a prolonged schedule in patients with previously untreated or relapsed/refractory follicular lymphoma. All patients received induction treatment with a standard course of 4-weekly rituximab infusions. Patients with stable disease or who were in partial or complete remission at week 12 were randomized in a 1:1 ratio to no further treatment or to treatment with rituximab for a prolonged period of time. Prolonged administration of rituximab improved the primary endpoint EFS when compared to observation alone. The difference in best response was not significant with 77% responders (31% CR) in the observation arm and 75% responders (38% CR) in the prolonged rituximab treatment arm. Responses were more durable in the prolonged rituximab treatment arm with an overall response rate after 1 year of 44% for patients on observation versus 60% for patients on prolonged rituximab treatment, respectively. The proportion of patients still responding at 2 years was 28% in the observation arm versus 45% in the prolonged rituximab arm. However, this study was too small to show any survival difference. Study LYM-5 This prospective, multi-center, community based, randomized study was aiming to compare the duration of rituximab benefit from maintenance treatment versus re-treatment at relapse in patients with relapsed indolent NHL. Patients who had received previous chemotherapy received one standard course of rituximab as induction treatment. Patients achieving a CR, PR or SD were randomly assigned to receive either rituximab maintenance therapy (375 mg/m2) with four weekly infusions given every 6 months for a maximum period of 18 months or rituximab re-treatment at the time of lymphoma progression (maximum of 4 rituximab courses including induction (375 mg/m2 weekly, x4). Out of these, 90 patients (79%) had an objective response or stable disease and were randomized to either maintenance rituximab (44 patients) or re-treatment (46 patients) with a standard 4-week rituximab course only at the time of lymphoma progression. The primary endpoint of the trial was the duration of rituximab benefit, defined as the period from the date of first treatment until the date that patients developed progressive lymphoma and required other treatment than rituximab. Patients were considered to benefit from rituximab treatment if they had ongoing or continuing responses of CR, PR or SD 6 months (for patients randomized to maintenance or re-treatment, respectively). Secondary endpoints included PFS, objective and complete response rate and overall survival. Median duration of rituximab benefit between the maintenance arm and the re-treatment arm was 31.3 months vs months. However, progression-free survival was significantly prolonged in the maintenance group with a median of 31.3 months vs. 7.4 months in the re-treatment group. In the maintenance group, initial ORR (39%) and CR (9%) rates increased to a best ORR of 52%, and a CR rate of 27%. In contrast, in patients retreated at progression minimal changes in overall response rates were observed and only 4% of patients achieved a CR at any time. More patients in the maintenance group had a continuous remission (20 vs. 11) and more patients were in ongoing complete remission (10 vs. 1) at the time of data cut-off. Overall survival was comparable between the arms. The design of this study is interesting as it compares maintenance treatment with rituximab in patients having a CR, PR and also a SD with re-treatment with rituximab following relapse. Therefore the benefit/risk of maintenance treatment can hardly be assessed. The study results are therefore of very limited value for the current application. The targeted patient number (n=100) was not reached. Therefore the study was underpowered for the primary endpoint. Second, there were imbalances between study arms for histology. All patients with SLL are expected to have less benefit form rituximab based on prior experience. Furthermore, the number of patients progressing before either maintenance or re-treatment was not balanced. In addition, the duration of rituximab benefit could not be properly assessed because rituximab re-treatment was not allowed for patient progressing after 7
8 successful completion of maintenance therapy but was allowed for patients in the re-treatment arm as long as they responded/did not progress after re-treatment. Studies in previously untreated patients Study U0824 Study U0824n was the first proof of concept for the efficacy and tolerability of rituximab maintenance treatment. The objective of this investigator-sponsored study was to assess response rates to singleagent rituximab in previously untreated patients with indolent NHL, and to evaluate in patients with objective response or stable disease after rituximab induction therapy, the feasibility, toxicity and efficacy of rituximab maintenance treatment with 4 weekly infusions of rituximab administered at 6- months intervals for up to 18 months. 60 patients (97%) completed the first 4- week cycle of rituximab and patients were re-staged for response. Those with an objective response or stable disease (n=46) continued in the study and received at least one course of rituximab maintenance treatment (4 x 375 mg/m2 weekly) every 6 months for a maximum of 18 months. 36 (58%) received the maximum of 4 courses in the trial. The objective response rate at 6 weeks after induction treatment was 47% with 7% complete response and 45% with stable disease. With continued maintenance treatment, the final response rate increased to 73%, with 37% complete response. In a recently published update with a median follow-up of 55 months, a median PFS of 37 months in the overall group was estimated. Importantly, the outcome in patients with follicular histology was significantly superior to that of patients with SLL. However, study U0824 was an early non-randomized study. Interpretation of results without inclusion of a control group is inherently difficult. Study ECOG 1496: This multicenter, randomized, phase III study conducted by ECOG included previously untreated patients with stage III-IV follicular lymphoma (grade 1 and 2) and small lymphocytic lymphoma. Patients were randomized to induction treatment with CVP or CF, stratified by age, histology, B symptoms and tumour burden. The CF arm was discontinued in September 2001 because of excessive toxicity, and the protocol was amended so that all subsequent patients received CVP induction treatment. Of a total of 516 recruited patients, 401 patients were treated with CVP to maximum response. 322 (80%) with a response or stable disease following CVP treatment was randomized to rituximab maintenance treatment (375 mg/m 2 weekly x 4) every 6 months for 4 cycles or no further treatment. Maintenance randomization was stratified by clinical residual disease and histology. Of 322 patients randomized to the maintenance phase, a total of 305 patients (157 rituximab and 148 observation) were assessable for efficacy. Patients randomized to rituximab maintenance and observation were well balanced for age, residual disease, histology and tumour burden as well as gender, stage, bone marrow involvement and international prognostic index. Patients were also well balanced with regard to their response to induction treatment. The study was terminated early as the O Brian-Fleming boundary for the primary endpoint of PFS was crossed in favour of the maintenance arm. 37 patients (24%) in the rituximab arm and 65 patients (44%) on observation had progressed or died. Rituximab maintenance therapy significantly prolonged median PFS in the overall population by 2.7 years (median PFS of 4.2 years for patients in the rituximab arm versus 1.5 years for patients under observation, p= ). Importantly, a significant prolongation of PFS was confirmed in subgroup analyses according to tumour burden, residual disease after induction treatment, histology and disease risk at baseline. Maintenance therapy with rituximab also improved the overall response rate after induction; 14% of patients had a complete response after CVP, which increased to 30% after maintenance therapy. In comparison, the increase in complete response rate for the observation arm increased from 16% after CVP to 22% after maintenance therapy. In the overall group, the risk of death was reduced by 40%, however this difference was only of borderline statistical significance. These differences in overall survival showed a strong trend in favour of maintenance therapy, but longer follow-up is needed to confirm these observations. ECOG 1496 was conducted in newly diagnosed patients, therefore in another patient category compared with pivotal study EORTC Nevertheless, the data indicate a highly statistically significant prolongation of PFS in the rituximab maintenance arm following CVP induction therapy. It 8
9 is also noted that this study does not include rituximab in the induction treatment which is now standard in combination with chemotherapy in previously untreated patients with follicular lymphoma. Discussion on Clinical Efficacy Rituximab maintenance significantly prolonged the median PFS for both patients responding to CHOP induction (11.6 months observation vs months rituximab, p<0.0001) and for patients responding to R-CHOP induction (22.1 months observation vs months rituximab, p=0.0071). The risk reduction for disease progression was more pronounced in patients who had received CHOP (71%, 95%CI 54% to 82%) compared to R-CHOP (46%, 95%CI 15% to 65%), probably due to the higher efficacy of R-CHOP as the induction regimen. Rituximab maintenance treatment also significantly prolonged the median PFS for patients with a CR (14.3 months observation vs months rituximab, p=0.0008) as well as for those with a PR (14.3 months observation vs months rituximab, p<0.0001). Amongst patients who achieved a CR following induction treatment, the risk reduction with rituximab maintenance treatment was 64% (95% CI: 33% to 81%) compared to 54% (95% CI: 33% to 69%) for those achieving a PR. This therefore emphasizes the need for an effective induction regimen to optimize the outcome with maintenance rituximab treatment. The open label nature of the pivotal EORTC trial with lack of a placebo control raised the possibility of bias in terms of assessment of progressive disease, e.g. similar scheduling of CT scans to assess progression in both treatment arms. The study protocol lacked detailed description of scheduled assessment of progression. In study EORTC no specific requirement regarding schedules CTscan assessment were prescribed in the protocol beyond the end of the induction phase (apparently tumour assessments were performed according to clinical practice which included 3 to 6-monthly CT scans in some, but not all participating sites). Although in accordance with published guidelines (Cheson et al) on follow up of NHL in clinical trials, accurate data on how often tumour progression was collected on the basis of clinical judgement or with imaging techniques (CT or MRI) is thus lacking. Although such potential lack of uniformity of tumour assessment may have created a potential bias as on the methodology (imaging or clinical assessment of tumour assessment during the maintenance phase was not collected on the CRF), it is however unlikely that this may have caused major bias, as during the maintenance phase, the same schedule of tumour assessments has been equally followed in both the observation and the maintenance arms of study EORTC Moreover, the demonstrated benefit in terms of overall survival in the pivotal EORTC trial (p=0.0039, log rank test), which represents a significant risk reduction for death by 56% (HR 0.44; 95% CI, ) in favour of the rituximab maintenance arm further confirms that the evaluation of the primary endpoint, progression-free survival in study EORTC was unbiased. MAH has thus adequately addressed this issue in the answer to question 1 in the request for supplementary information. Although the maintenance schedules used in the submitted studies were heterogeneous available pharmacodynamic data suggest that significant B cell depletion can be achieved with either schedule of rituximab maintenance treatment: 2-3 monthly single infusions or 4 weekly infusions administered every 6 months. B cell recovery after administration of a single rituximab infusion every 2-3 months seems to occur earlier than after the administration of 4-weekly infusions every 6 months. However a final conclusion regarding the degree of B cell depletion with the different rituximab schedules cannot be drawn. More importantly, available data do not provide information on the level of B-cell depletion needed for clinical benefit. Regardless of dosing schedule chosen by different collaborative study groups, all trials demonstrated a significant benefit with rituximab maintenance treatment compared to observation. The value of data on symptomatic progression to provide additional support for the clinical benefit of rituximab maintenance treatment is recognised. However, currently there is no validated symptom related parameter specific to follicular lymphoma for use in clinical trials. Taking into account the accepted clinical practice that only symptomatic follicular lymphoma patients should be treated with therapeutic agents, time to new lymphoma treatment or death (TNLT) represents an alternative 9
10 parameter to assess the clinical benefit of a specific therapeutic regimen. We agree that a delay in disease progression of 28 months, time to new lymphoma treatment by 19 months and a risk reduction for death by 56% with rituximab maintenance when compared to observation is likely to represent a clinically significant symptomatic benefit. For patients with relapsed/refractory follicular lymphoma not previously treated with rituximab and responding to induction therapy with CHOP or R-CHOP, maintenance treatment with rituximab offers a statistically significant and clinically meaningful improvement in progression-free and overall survival. The benefit is greater for patients who are not treated with rituximab in the induction phase, but the benefit is significant and meaningful also for patients who are treated with rituximab in the induction phase. For patients with relapsed/refractory follicular lymphoma not previously treated with rituximab the claimed indication has thus been shown to be valid. However, in the future most patients with follicular lymphoma will be treated with rituximab as primary treatment hence the number of patients fulfilling the criteria at relapse will decrease dramatically. It is true that the majority of follicular lymphomas maintain continued sensitivity to repeated courses of treatment even with the same agent(s) after the first 2-3 relapses. The evidence quoted by the applicant (study 8426) is a retrospective study of patients treated with induction chemotherapy only. There are in vitro data (studies 8229 and 8145) showing that MabThera re-sensitises resistant lymphoma cell lines to cytotoxic agents. The extrapolation of the available data to patients who received MabThera up front as part of the primary treatment was extensively discussed. The only study referred to which deals with MabThera maintenance is the GLSG-FCM Study, where nine patients were treated with a MabThera containing induction regimen initially and at relapse, followed by MabThera maintenance. This number of patients is clearly too small for any conclusions to be drawn. Although results seem promising, proper randomized evidence should be produced, in order to be able to assess the impact on overall and progression free survival. The large amount of scientific data being available on the nature of the disease and the efficacy of MabThera in NHL, especially in re-treatment, form the basis of the medical practice for treating NHL in Europe: According to various treatment guidelines, repeated usage of the same regimen at the time of relapse is recommended, if initial response to that regimen was longlasting (>= 6 or 12 months) (National Comprehensive Cancer Network (NCCN), Cancer Care Ontario (CCO), Seyfarth et al, BJH 2006; Maloney et al, Curr Hematol Rep 2005). For MabThera, a number of trials published over the last years have demonstrated efficacy of retreatment in various clinical settings. Therefore, MabThera re-treatment has also been incorporated into several treatment guidelines and has been widely adopted into clinical practice for the management of patients with relapsed follicular NHL responding to a prior course of MabThera. Available data from the GLSG study as well as individual case reports published in the literature (e.g. Cohen et al, The Hematol Journal, 2003) suggest a benefit from maintenance therapy following MabThera plus chemotherapy induction treatment also in patients who have relapsed after a prior MabThera-containing first-line treatment. Based on these data and the efficacy of MabThera re-treatment, there is a lack of scientific interest in the lymphoma community (see below) to address the question of MabThera maintenance benefit in patients failing after MabThera-containing first-line treatment. Therefore, no randomized study is currently ongoing or planned in this setting and no data from a randomized study will be available in the future. Given the high medical need for better treatment options in relapsed/refractory disease, the medical community represented by an international panel of lymphoma experts from key lymphoma study groups (International Advisory Board Meeting, May 2006) considered the usage of MabThera maintenance treatment appropriate in patients relapsing after MabTheracontaining first line therapy. It was assumed that a MabThera-containing first-line regimen given in median 3-4 years before disease progression would not impact on the efficacy of maintenance therapy at relapse, especially if the patient responds to re-induction therapy with MabThera and 10
11 chemotherapy. It was recognized that the clinical evidence for maintenance treatment in the setting of MabThera pre-treated patients is very limited and the exact magnitude of the treatment effect of maintenance is not known. However, it was considered that the large efficacy benefit with MabThera maintenance therapy resulting in improved overall survival in relapsed follicular lymphoma with a favorable safety profile demonstrated in various clinical settings strongly supports maintenance usage in the entire group of relapsed patients, including MabThera pretreated patients. According to lymphoma treating physicians (market research on the usage of MabThera maintenance therapy in follicular lymphoma conducted by the MAH in 2005), the main reasons to exclude patients failing after prior MabThera-containing therapy from maintenance treatment would be toxicity, known allergy, and inappropriate histology. The only reason for not considering MabThera maintenance treatment for management of relapsed disease relating to prior therapy would be if the patient had relapsed while or within 6 months following prior MabThera-containing therapy. An extrapolation of the effect of MabThera maintenance to patients receiving primary treatment with MabThera plus chemotherapy is not valid. It is argued that because MabThera maintenance improves outcome after primary induction therapy with either MabThera monotherapy or with chemotherapy without MabThera, and because MabThera maintenance improves outcome in patients responding to relapse treatment with chemotherapy with or without MabThera, then MabThera maintenance must also improve outcome after primary treatment with today s standard treatment, i.e. a combination of chemotherapy and MabThera. It is very likely that MabThera maintenance in this setting will offer some improvement. It is true that the population of patients with follicular lymphoma is heterogeneous, and that testing a specific regimen in every thinkable scenario is impossible. However, it would seem a reasonable request to demand evidence of the magnitude and clinical importance of the benefit of maintenance MabThera in the scenario which is now the standard primary treatment of these patients (some form of chemotherapy combined with MabThera), a treatment which has yielded a significant benefit compared with previous treatments. The MAH refers to analyses of subgroups of patients in the pivotal trial (EORTC 20981) who had had limited prior therapy and who got MabThera containing induction treatment for relapse followed by +/- MabThera maintenance. These analyses point in the direction of a benefit of MabThera maintenance in this situation. Study MO18264 (PRIMA Study Primary Rituximab and Maintenance) is an open-label, international, randomized, multi-center phase III study which has been enrolling patients since end of December The study is evaluating the efficacy of rituximab maintenance treatment in previously untreated patients with follicular lymphoma responding to an induction treatment with rituximab and chemotherapy. This trial was initiated and is sponsored (in Europe) by the Groupe d Etudes des Lymphomes d Adultes (GELA). Six hundred and forty patients will be included in the trial and 480 patients are expected to be randomized to rituximab maintenance versus observation. There are two planned interim efficacy analyses (after 50% and 75% of events). Final results are expected to be available in 3-4 years. The safety data emerging from this study is periodically reviewed by an independent Data and Safety Monitoring Board (DSMB). After the first review meeting (January 26, 2006), the DSMB recommended to continue the trial unchanged. Upon request, regular updates on the outcomes from DSMB meetings, i.e. meeting minutes from the open part of the session would be available for submission to the regulatory authorities in the future as well as a clinical study report once available after the final analysis. The results of the PRIMA trial is expected to provide additional evidence Clinical safety The main data source for safety information for rituximab as maintenance treatment in patients with follicular NHL comes from the pivotal study, EORTC (Roche study M39022). Safety data is available from this study on 332 patients with relapsed/refractory follicular lymphoma who responded to induction treatment with CHOP or R-CHOP and who received up to 8 cycles of rituximab maintenance treatment or observation for a maximum period of 2 years. At the time of the final 11
12 analysis, 119 patients in the safety population (40 observation, 79 rituximab) had completed the scheduled maintenance periods. More patients in the rituximab arm (47%) completed the scheduled 8 treatment periods (i.e. 2 years) compared with the observation arm (24%). The main reason for this was that more patients in the observation arm had progressed. However, an updated analysis should be submitted with focus on infections. Limited safety information is available in the literature from the five other completed studies of rituximab in the maintenance setting mentioned previously. Overall, the safety results reported in these studies are consistent with the known safety profile of rituximab and no new or unexpected toxicities were seen during the use of rituximab in the maintenance setting. Overall, more than 400 patients were randomized to receive maintenance rituximab, although the dosing schedules were different from that used in study EORTC Safety information (including serious adverse events) from the global rituximab safety database is also available. The overall safety profile of rituximab in the maintenance setting was consistent with its expected safety profile. All grades AEs, related AEs, grades 3 and 4 AEs and SAEs were reported at higher incidence in the rituximab arm (see Table below). The overall incidence of serious IRRs in the rituximab arm was low (<1%) and few patients discontinued treatment for safety reasons. Seven patients died during the active part of the maintenance phase, with the most common cause being disease progression. Importantly, no patient died due to toxicity while on active treatment/observation. Overview of the Safety - Maintenance Phase Study EORTC Observation N=166 Rituximab N=166 All NCIC CTC AEs 130 (78%) 149 (90%) Related NCIC CTC AEs 91 (55%) 128 (77%) Grade 3/4 NCIC CTC AEs 38 (23%) 61 (37%) Serious AEs 1 (<1%) 22 (13%) Serious IRR - 1 (<1%) Toxicity related Withdrawals - 6 (4%) Deaths (not treatment related) 3 (2%) 4 (2%) Flu-like symptoms (mainly lethargy, myalgia, arthralgia and fever) were reported more often in the rituximab arm. Furthermore, neurologic, infections (related to leucopenia and neutropenia, pulmonary events (cough and shortness of breath) other and allergies were more often reported in the rituximab arm. There was a higher incidence in grade 3 or 4 toxicities for blood/bone marrow and for infection. The proportion of patients that experienced at least one infection was 22% in the observation arm and 43% in the rituximab arm. At the time of the final analysis, 119 patients in the safety population (40 observation, 79 rituximab) had completed the scheduled maintenance periods. More patients in the rituximab arm (47%) completed the scheduled 8 treatment periods (i.e. 2 years) compared with the observation arm (24%). In both study arms, the proportion of patients reporting AEs was highest in the first period and tended to decrease (notably from around period 3) over time although the magnitude of the decrease was smaller in the rituximab arm. For instance, the proportion of patients reporting AEs in period 1 was 62% observation vs. 72% rituximab compared with 37% observation and 50% rituximab in the last treatment period (period 8). The higher incidence of AEs in the early periods in both arms probably reflects toxicity associated with the induction treatment. Importantly, there was no evidence of cumulative toxicity over time in the rituximab arm. Grade 3 or 4 Adverse Events More patients on rituximab (37%) compared with observation (23%) experienced at least one grade 3 or 4 AE. This difference is mainly accounted for by a higher incidence in grade 3 or 4 toxicities for blood/bone marrow and for infection. 12
13 The incidence of grade 3 or 4 gastrointestinal AEs were slightly higher with rituximab whereas grade 3 or 4 flu-like symptoms were unexpectedly more common in the observation arm. This might be a reflection of poorer control of the underlying disease in patients in the observation arm, or it might simply be a result of small numbers and chance. There were no other relevant differences between the treatment groups with respect to the incidence and type of other grade 3 or 4 AEs. Deaths At the time of the cut-off for the final analysis (December 31, 2004), a total of seven patients randomized to the maintenance phase of the study (3 observation, 4 rituximab) had died during active observation or maintenance. The causes of death were lymphoma related for 3 patients (2 observation, 1 rituximab), infections for 3 patients (1 observation, 2 rituximab) and cardiovascular disease for one patient on rituximab. Importantly, no deaths were considered as treatment-related. Discussion on clinical safety The overall safety profile of rituximab in the maintenance setting was consistent with its expected safety profile. All grades AEs, related AEs, grades 3 and 4 AEs and SAEs were reported at higher incidence in the rituximab arm (see Table below). The overall incidence of serious IRRs in the rituximab arm was low (<1%) and few patients discontinued treatment for safety reasons. Seven patients died during the active part of the maintenance phase, with the most common cause being disease progression. Importantly, no patient died due to toxicity while on active treatment/observation. An updated safety analysis (data cut off of March 13, 2006) indicates that overall the safety profile of rituximab confirmed the safety profile as described in the CSR with no new of unexpected adverse events reported. No new death was reported during the active observation or maintenance phase of the study. One additional patient withdrew form rituximab maintenance therapy due to toxicity. No change was observed in terms of frequency, type or severity of infections during the rituximab maintenance. The next updated safety analysis of study EORTC is planned when all patients randomized to the maintenance phase have completed the maintenance/observation phase (expected first half 2007). These updated safety data with emphasis on infections and secondary tumours are requested to address longer term safety as a result from B-lymphocyte depletion. 3. BENEFIT RISK ASSESSMENT Follicular lymphoma usually presents with widespread disease at the time of diagnosis. Although the disease generally follows an indolent course, with a median survival of 8-10 years from diagnosis, it is considered to be incurable with currently available treatments. Initial response rates to chemotherapy are typically high, but are followed inevitably by relapse. Subsequent treatments after relapse still achieve remissions, but at progressively lower rates and of shorter durations. Over the course of the disease, a patient with follicular lymphoma usually receives between 3 and 7 different treatment regimens of varying intensities. Standard treatment consists of single or multidrug chemotherapy, which is today usually combined with anti-cd20 antibodies. The problem is obtaining durable remissions. The maintenance treatment with rituximab of patients with follicular lymphoma responding to induction therapy significantly improves progression-free and overall survival. The claim is made regardless of whether the patient has previously untreated disease or relapsed/refractory disease, regardless of which induction treatment regimen was employed, and regardless of whether rituximab has been given as part of the induction treatment (in previously untreated patients) or as part of earlier regimens (in patients with relapsed/refractory disease). The primary data for this application is based on results from Study EORTC This study was prospectively planned, adequately controlled, centrally randomized and multicentre in nature. The results achieved with rituximab maintenance were consistently observed for all primary and secondary 13
14 endpoints. A significant improvement in the primary endpoint, progression free survival (PFS), was also shown for rituximab maintenance therapy compared to observation (42.2 months versus observation, 14.3 months (p<0.0001). This large prolongation in PFS translates into a significantly reduced risk of death or disease progression with maintenance rituximab: all-cause mortality was reduced by 56% (95% CI 22-75%) when compared to observation alone. The supportive studies, published studies have tested maintenance treatment in various clinical setting and with various rituximab regimens. Despite multiple differences with pivotal study EORTC and heterogeneity in terms of patient population included, induction regimen prior to maintenance treatment dosing schedule of rituximab, the studies quoted document a significant improvement in progression-free survival and overall survival from maintenance rituximab in previously untreated patients responding to a non-rituximab containing induction regimen. The studies quoted also document a significant improvement in progression-free and overall survival in relapsed/refractory follicular lymphoma who have never been treated with rituximab before and who respond to induction therapy with or without rituximab. The positive effects discussed above should be weighed against the increased incidence of adverse events in rituximab treated patients. Overall incidence of infections was higher in the rituximab arm (43%) compared to the observation arm (22%). In addition infusion related reactions such as allergy and flu-like symptoms were more common in the rituximab arms. Adverse events of grade 3 or 4 severity were reported for 23% and 37% of patients in the observation and rituximab arms respectively. The only grade 3 to 4 events with a higher incidence in the rituximab arms were blood/bone marrow disorders (higher incidence of leucopenia and neutropenia) and infections. In addition there is uncertainty about long term safety, in particular related to prolonged B cell depletion. An updated safety analysis (data cut off of March 13, 2006) indicates that overall the safety profile of rituximab confirmed the safety profile as described in the CSR with no new of unexpected adverse events reported. No new death was reported during the active observation or maintenance phase of the study. One additional patient withdrew form rituximab maintenance therapy due to toxicity. No change was observed in terms of frequency, type or severity of infections during the rituximab maintenance. The next updated safety analysis of study EORTC is planned when all patients randomized to the maintenance phase have completed the maintenance/observation phase (expected first half 2007). Such updated safety results with emphasis on infections and secondary tumours are requested to address longer-term safety as a result from B-lymphocyte depletion. A post-authorisation Risk Management Plan is proposed, including an already existing Human Safety Database containing as of August 2005 over 7,000 reports of adverse events with rituximab monotherapy or combination immunochemotherapy. Potential risks for rituximab maintenance therapy have been identified (infusion-related reactions, infections, neutropenia, delayed B cell recovery) and action plans are proposed. An increased risk of second malignancies due to rituximab is expected to be small. Considering the limited life expectancy of patients with advanced follicular lymphoma, the clinical significance of any increased risk of second malignancies is expected to be small. Ongoing trials (e.g. the very recently initiated PRIMA study (A multicentre, phase III, open label, randomized study in patients with advanced follicular lymphoma evaluating the benefit of maintenance therapy with Rituximab (MabThera) after induction of response with chemotherapy plus Rituximab in comparison with no maintenance therapy) should demonstrate the benefit of rituximab maintenance in previously untreated patients. 4. CONCLUSION On 1 June 2006 the CHMP considered this Type II variation to be acceptable and agreed on the amendments to be introduced in the Summary of Product Characteristics, Annex II, Labelling and Package Leaflet. 14
15 Follow-up measures undertaken by the Marketing Authorisation Holder As requested by the CHMP, the MAH agreed to submit the follow-up measures as listed below and to submit any variation application which would be necessary in the light of compliance with these commitments (see Letter of Undertaking attached to this report): Area 1 Description Due date 2 Clinical EORTC study: Submission of an updated safety analysis Q3/2007 of study EORTC when all patients randomized to the maintenance phase have completed the maintenance/observation phase Clinical MO18264 study (PRIMA): submission of final study report when available Estimated Q4/ Areas: Quality, Non-clinical, Clinical, Pharmacovigilance 2. Due date for the follow-up measure or for the first interim report if a precise date cannot be committed to.. 15
CHAPTER 26 LATE BREAKING DEVELOPMENTS: IMPACT OF ANTI-CD20 MONOCLONAL ANTIBODIES ON LYMPHOMA THERAPY
 CHAPTER 26 LATE BREAKING DEVELOPMENTS: IMPACT OF ANTI-CD20 MONOCLONAL ANTIBODIES ON LYMPHOMA THERAPY 26.1 Introduction rituximab Subsequent to the completion of drafts for the guidelines earlier in 2004,
CHAPTER 26 LATE BREAKING DEVELOPMENTS: IMPACT OF ANTI-CD20 MONOCLONAL ANTIBODIES ON LYMPHOMA THERAPY 26.1 Introduction rituximab Subsequent to the completion of drafts for the guidelines earlier in 2004,
EVIDENCE IN BRIEF OVERALL CLINICAL BENEFIT
 perc also deliberated on the alignment of bendamustine with patient values. perc noted that bendamustine has a progression-free survival advantage, may be less toxic than currently available therapies
perc also deliberated on the alignment of bendamustine with patient values. perc noted that bendamustine has a progression-free survival advantage, may be less toxic than currently available therapies
FDA approves Rituxan/MabThera for first-line maintenance use in follicular lymphoma
 Media Release Basel, 31 January 2011 FDA approves Rituxan/MabThera for first-line maintenance use in follicular lymphoma Approval provides option that improves the length of time people with incurable
Media Release Basel, 31 January 2011 FDA approves Rituxan/MabThera for first-line maintenance use in follicular lymphoma Approval provides option that improves the length of time people with incurable
David Loew, LCL MabThera
 MabThera The star continues to rise David Loew, LCL MabThera MabThera the star continues to raise Group sales (CHF bn) 4,5 4,0 3,5 3,0 2,5 2,0 1,5 1,0 0,5 0,0 2001 2002 2003 2004 2005 Outstanding clinical
MabThera The star continues to rise David Loew, LCL MabThera MabThera the star continues to raise Group sales (CHF bn) 4,5 4,0 3,5 3,0 2,5 2,0 1,5 1,0 0,5 0,0 2001 2002 2003 2004 2005 Outstanding clinical
Lenalidomide (LEN) in Patients with Transformed Lymphoma: Results From a Large International Phase II Study (NHL-003)
 Lenalidomide (LEN) in Patients with Transformed Lymphoma: Results From a Large International Phase II Study (NHL-003) Reeder CB et al. Proc ASCO 2010;Abstract 8037. Introduction > Patients (pts) with low-grade
Lenalidomide (LEN) in Patients with Transformed Lymphoma: Results From a Large International Phase II Study (NHL-003) Reeder CB et al. Proc ASCO 2010;Abstract 8037. Introduction > Patients (pts) with low-grade
Rituximab Maintenance for 2 Years in Patients with Untreated High Tumor Burden Follicular Lymphoma After Response to Immunochemotherapy
 Rituximab Maintenance for 2 Years in Patients with Untreated High Tumor Burden Follicular Lymphoma After Response to Immunochemotherapy G. A. Salles, J. F. Seymour, P. Feugier, F. Offner, A. Lopez-Guillermo,
Rituximab Maintenance for 2 Years in Patients with Untreated High Tumor Burden Follicular Lymphoma After Response to Immunochemotherapy G. A. Salles, J. F. Seymour, P. Feugier, F. Offner, A. Lopez-Guillermo,
New Targets and Treatments for Follicular Lymphoma. Disclosures
 Winship Cancer Institute of Emory University New Targets and Treatments for Follicular Lymphoma Jonathon B. Cohen, MD, MS Assistant Professor Div of BMT, Emory University Disclosures Consulting fees from:
Winship Cancer Institute of Emory University New Targets and Treatments for Follicular Lymphoma Jonathon B. Cohen, MD, MS Assistant Professor Div of BMT, Emory University Disclosures Consulting fees from:
rituximab 1400mg solution for subcutaneous injection (Mabthera ) SMC No. (975/14) Roche Products Limited
 rituximab 1400mg solution for subcutaneous injection (Mabthera ) SMC No. (975/14) Roche Products Limited 06 June 2014 The Scottish Medicines Consortium (SMC) has completed its assessment of the above product
rituximab 1400mg solution for subcutaneous injection (Mabthera ) SMC No. (975/14) Roche Products Limited 06 June 2014 The Scottish Medicines Consortium (SMC) has completed its assessment of the above product
Therapeutic Options in Refractory or Relapsed CD20-positive Follicular Lymphoma
 a report by Martin Dreyling Therapeutic Options in Refractory or Relapsed CD20-positive Follicular Lymphoma Head, Lymphoma Section, Department of Medicine III, University Hospital Großhadern, Ludwig Maximilians-University
a report by Martin Dreyling Therapeutic Options in Refractory or Relapsed CD20-positive Follicular Lymphoma Head, Lymphoma Section, Department of Medicine III, University Hospital Großhadern, Ludwig Maximilians-University
Frequency of NHL Subtypes in Adults
 Chemotherapy Options Stephanie A. Gregory, M.D. The Elodia Kehm Professor of Medicine Director, Section of Hematology Rush University Medical Center Chicago, Illinois Frequency of NHL Subtypes in Adults
Chemotherapy Options Stephanie A. Gregory, M.D. The Elodia Kehm Professor of Medicine Director, Section of Hematology Rush University Medical Center Chicago, Illinois Frequency of NHL Subtypes in Adults
Avastin in Metastatic Breast Cancer
 Non-interventional study Avastin in Metastatic Breast Cancer ML 21165 / 2007 Clinical Study Report Synopsis ROCHE ML21165 / WiSP Project RH09 / V. 1.0 / 24.06.2013 ROCHE ML21165-2 - Name of Sponsor Roche
Non-interventional study Avastin in Metastatic Breast Cancer ML 21165 / 2007 Clinical Study Report Synopsis ROCHE ML21165 / WiSP Project RH09 / V. 1.0 / 24.06.2013 ROCHE ML21165-2 - Name of Sponsor Roche
Bendamustine with rituximab for the first-line treatment of advanced indolent non-hodgkin's and mantle cell lymphoma
 LONDON CANCER NEW DRUGS GROUP RAPID REVIEW Bendamustine with rituximab for the first-line treatment of advanced indolent non-hodgkin's and mantle cell lymphoma Bendamustine with rituximab for the first-line
LONDON CANCER NEW DRUGS GROUP RAPID REVIEW Bendamustine with rituximab for the first-line treatment of advanced indolent non-hodgkin's and mantle cell lymphoma Bendamustine with rituximab for the first-line
IF AT FIRST YOU DON T SUCCEED: TRIAL, TRIAL AGAIN
 + IF AT FIRST YOU DON T SUCCEED: TRIAL, TRIAL AGAIN Rena Buckstein MD FRCPC Head Hematology Site Group Sunnybrook Odette Cancer Center (OCC) Head of Hematology Clinical Trials Group at OCC + Outline Start
+ IF AT FIRST YOU DON T SUCCEED: TRIAL, TRIAL AGAIN Rena Buckstein MD FRCPC Head Hematology Site Group Sunnybrook Odette Cancer Center (OCC) Head of Hematology Clinical Trials Group at OCC + Outline Start
DECISION AND SUMMARY OF RATIONALE
 DECISION AND SUMMARY OF RATIONALE Indication under consideration Clinical evidence Clofarabine in the treatment of relapsed acute myeloid leukaemia (AML) The application was for clofarabine to remain in
DECISION AND SUMMARY OF RATIONALE Indication under consideration Clinical evidence Clofarabine in the treatment of relapsed acute myeloid leukaemia (AML) The application was for clofarabine to remain in
Sonneveld, P; de Ridder, M; van der Lelie, H; et al. J Clin Oncology, 13 (10) : 2530-2539 Oct 1995
 Comparison of Doxorubicin and Mitoxantrone in the Treatment of Elderly Patients with Advanced Diffuse Non-Hodgkin's Lymphoma Using CHOP Versus CNOP Chemotherapy. Sonneveld, P; de Ridder, M; van der Lelie,
Comparison of Doxorubicin and Mitoxantrone in the Treatment of Elderly Patients with Advanced Diffuse Non-Hodgkin's Lymphoma Using CHOP Versus CNOP Chemotherapy. Sonneveld, P; de Ridder, M; van der Lelie,
Guidelines for the use of Rituximab in Non-Hodgkin s Lymphoma QEII Health Sciences Centre
 Guidelines for the use of Rituximab in Non-Hodgkin s Lymphoma QEII Health Sciences Centre Background Non-Hodgkin s lymphoma (NHL) makes up approximately 85% of all lymphomas. They are a heterogeneous collection
Guidelines for the use of Rituximab in Non-Hodgkin s Lymphoma QEII Health Sciences Centre Background Non-Hodgkin s lymphoma (NHL) makes up approximately 85% of all lymphomas. They are a heterogeneous collection
Histopathologic results
 Self evaluation 1 Clinical Case 55-year-old woman Bilateral enlargement of cervical, axillary and inguinal lymph nodes, largest diameter > 6 cm Hepatosplenomegaly. Enlargement of retroperitoneal, mesenteric
Self evaluation 1 Clinical Case 55-year-old woman Bilateral enlargement of cervical, axillary and inguinal lymph nodes, largest diameter > 6 cm Hepatosplenomegaly. Enlargement of retroperitoneal, mesenteric
Guidelines for the Management of Follicular Lymphoma
 Guidelines for the Management of Follicular Lymphoma Scope The following guidance for first- and second-line therapy applies to follicular lymphoma histological grades 1, 2 and 3a according to the World
Guidelines for the Management of Follicular Lymphoma Scope The following guidance for first- and second-line therapy applies to follicular lymphoma histological grades 1, 2 and 3a according to the World
Mantle Cell Lymphoma Understanding Your Treatment Options
 New Developments in Mantle Cell Lymphoma John P. Leonard, M.D. Richard T. Silver Distinguished Professor of Hematology and Medical Oncology Associate Dean for Clinical Research Vice Chairman, Department
New Developments in Mantle Cell Lymphoma John P. Leonard, M.D. Richard T. Silver Distinguished Professor of Hematology and Medical Oncology Associate Dean for Clinical Research Vice Chairman, Department
Are CAR T-Cells the Solution for Chemotherapy Refractory Diffuse Large B-Cell Lymphoma? Umar Farooq, MD University of Iowa Hospitals and Clinics
 Are CAR T-Cells the Solution for Chemotherapy Refractory Diffuse Large B-Cell Lymphoma? Umar Farooq, MD University of Iowa Hospitals and Clinics Disclosure(s) I do not intend to discuss an off-label use
Are CAR T-Cells the Solution for Chemotherapy Refractory Diffuse Large B-Cell Lymphoma? Umar Farooq, MD University of Iowa Hospitals and Clinics Disclosure(s) I do not intend to discuss an off-label use
Effective for dates of service on or after September 1, 2015, refer to: https://www.bcbsal.org/providers/drugpolicies/index.cfm
 Effective for dates of service on or after September 1, 2015, refer to: https://www.bcbsal.org/providers/drugpolicies/index.cfm Name of Policy: Uses of Monoclonal Antibodies for the Treatment of Non-Hodgkin
Effective for dates of service on or after September 1, 2015, refer to: https://www.bcbsal.org/providers/drugpolicies/index.cfm Name of Policy: Uses of Monoclonal Antibodies for the Treatment of Non-Hodgkin
Van Cutsem E et al. Proc ASCO 2009;Abstract LBA4509.
 Efficacy Results from the ToGA Trial: A Phase III Study of Trastuzumab Added to Standard Chemotherapy in First-Line HER2- Positive Advanced Gastric Cancer Van Cutsem E et al. Proc ASCO 2009;Abstract LBA4509.
Efficacy Results from the ToGA Trial: A Phase III Study of Trastuzumab Added to Standard Chemotherapy in First-Line HER2- Positive Advanced Gastric Cancer Van Cutsem E et al. Proc ASCO 2009;Abstract LBA4509.
CAR T cell therapy for lymphomas
 CAR T cell therapy for lymphomas Sattva S. Neelapu, MD Associate Professor and Deputy Chair ad interim Department of Lymphoma and Myeloma UT MD Anderson Cancer Center, Houston, TX CAR T cell therapy What
CAR T cell therapy for lymphomas Sattva S. Neelapu, MD Associate Professor and Deputy Chair ad interim Department of Lymphoma and Myeloma UT MD Anderson Cancer Center, Houston, TX CAR T cell therapy What
Rituximab in Non - Hodgkins Lymphoma. Fatima Bassa, Dept. of Haematology October 2008
 Rituximab in Non - Hodgkins Lymphoma Fatima Bassa, Dept. of Haematology October 2008 World Health Organization lymphoma classification (2001) Peripheral B-cell neoplasms: B-chronic lymphocytic leukemia/small
Rituximab in Non - Hodgkins Lymphoma Fatima Bassa, Dept. of Haematology October 2008 World Health Organization lymphoma classification (2001) Peripheral B-cell neoplasms: B-chronic lymphocytic leukemia/small
Treatment of low-grade non-hodgkin lymphoma
 Produced 28.02.2011 Due for revision 28.02.2013 Treatment of low-grade non-hodgkin lymphoma Lymphomas are described as low grade if the cells appear to be dividing slowly. There are several kinds of low-grade
Produced 28.02.2011 Due for revision 28.02.2013 Treatment of low-grade non-hodgkin lymphoma Lymphomas are described as low grade if the cells appear to be dividing slowly. There are several kinds of low-grade
Aggressive lymphomas. Michael Crump Princess Margaret Hospital
 Aggressive lymphomas Michael Crump Princess Margaret Hospital What are the aggressive lymphomas? Diffuse large B cell Mediastinal large B cell Anaplastic large cell Burkitt lymphoma (transformed lymphoma:
Aggressive lymphomas Michael Crump Princess Margaret Hospital What are the aggressive lymphomas? Diffuse large B cell Mediastinal large B cell Anaplastic large cell Burkitt lymphoma (transformed lymphoma:
Rituximab for the treatment of relapsed or refractory stage III or IV follicular non-hodgkin s lymphoma
 DOI: 10.3310/hta13suppl2/06 Health Technology Assessment 2009; Vol. 13: Suppl. 2 Rituximab for the treatment of relapsed or refractory stage III or IV follicular non-hodgkin s lymphoma A Boland, A Bagust,
DOI: 10.3310/hta13suppl2/06 Health Technology Assessment 2009; Vol. 13: Suppl. 2 Rituximab for the treatment of relapsed or refractory stage III or IV follicular non-hodgkin s lymphoma A Boland, A Bagust,
Réda Bouabdallah, MD Institut Paoli-Calmettes, Marseille, France. Oran, May, 8th, 2010
 FIRST LINE TREATMENT IN FOLLICULAR LYMPHOMA Current Status Réda Bouabdallah, MD Institut Paoli-Calmettes, Marseille, France Oran, May, 8th, 2010 FL is a complex disease One disease, but many profiles 20%
FIRST LINE TREATMENT IN FOLLICULAR LYMPHOMA Current Status Réda Bouabdallah, MD Institut Paoli-Calmettes, Marseille, France Oran, May, 8th, 2010 FL is a complex disease One disease, but many profiles 20%
Lauren Berger: Why is it so important for patients to get an accurate diagnosis of their blood cancer subtype?
 Hello, I m Lauren Berger and I m the Senior Director of Patient Services Programs at The Leukemia & Lymphoma Society. I m pleased to welcome Dr. Rebecca Elstrom. Dr. Elstrom is an Assistant Professor in
Hello, I m Lauren Berger and I m the Senior Director of Patient Services Programs at The Leukemia & Lymphoma Society. I m pleased to welcome Dr. Rebecca Elstrom. Dr. Elstrom is an Assistant Professor in
In non-hodgkin s lymphoma, MabThera is used to treat two types of the disease, both of which affect B-lymphocytes:
 EMA/614203/2010 EMEA/H/C/000165 EPAR summary for the public rituximab This is a summary of the European public assessment report (EPAR) for. It explains how the Committee for Medicinal Products for Human
EMA/614203/2010 EMEA/H/C/000165 EPAR summary for the public rituximab This is a summary of the European public assessment report (EPAR) for. It explains how the Committee for Medicinal Products for Human
1.0 Abstract. Title: Real Life Evaluation of Rheumatoid Arthritis in Canadians taking HUMIRA. Keywords. Rationale and Background:
 1.0 Abstract Title: Real Life Evaluation of Rheumatoid Arthritis in Canadians taking HUMIRA Keywords Rationale and Background: This abbreviated clinical study report is based on a clinical surveillance
1.0 Abstract Title: Real Life Evaluation of Rheumatoid Arthritis in Canadians taking HUMIRA Keywords Rationale and Background: This abbreviated clinical study report is based on a clinical surveillance
Outline of thesis and future perspectives.
 Outline of thesis and future perspectives. This thesis is divided into two different sections. The B- section involves reviews and studies on B- cell non- Hodgkin lymphoma [NHL] and radioimmunotherapy
Outline of thesis and future perspectives. This thesis is divided into two different sections. The B- section involves reviews and studies on B- cell non- Hodgkin lymphoma [NHL] and radioimmunotherapy
January 2013 LONDON CANCER NEW DRUGS GROUP RAPID REVIEW. Summary. Contents
 LONDON CANCER NEW DRUGS GROUP RAPID REVIEW Paclitaxel albumin (Abraxane ) as a substitute for docetaxel/paclitaxel for cancer Paclitaxel albumin (Abraxane ) as a substitute for docetaxel/ paclitaxel for
LONDON CANCER NEW DRUGS GROUP RAPID REVIEW Paclitaxel albumin (Abraxane ) as a substitute for docetaxel/paclitaxel for cancer Paclitaxel albumin (Abraxane ) as a substitute for docetaxel/ paclitaxel for
Severe rheumatoid arthritis (a disease that causes inflammation of the joints),where MabThera is given intravenously together with methotrexate.
 EMA/614203/2010 EMEA/H/C/000165 EPAR summary for the public rituximab This is a summary of the European public assessment report (EPAR) for. It explains how the Committee for Medicinal Products for Human
EMA/614203/2010 EMEA/H/C/000165 EPAR summary for the public rituximab This is a summary of the European public assessment report (EPAR) for. It explains how the Committee for Medicinal Products for Human
New Evidence reports on presentations given at EULAR 2012. Rituximab for the Treatment of Rheumatoid Arthritis
 New Evidence reports on presentations given at EULAR 2012 Rituximab for the Treatment of Rheumatoid Arthritis Report on EULAR 2012 presentations Long-term safety of rituximab: 10-year follow-up in the
New Evidence reports on presentations given at EULAR 2012 Rituximab for the Treatment of Rheumatoid Arthritis Report on EULAR 2012 presentations Long-term safety of rituximab: 10-year follow-up in the
Rituximab for the treatment of relapsed or refractory stage III or IV follicular non-hodgkin's lymphoma: Review of technology appraisal guidance 37
 Rituximab for the treatment of relapsed or refractory stage III or IV follicular non-hodgkin's lymphoma: Review of technology appraisal Issued: February 2008 guidance.nice.org.uk/ta NICE 2008 Contents
Rituximab for the treatment of relapsed or refractory stage III or IV follicular non-hodgkin's lymphoma: Review of technology appraisal Issued: February 2008 guidance.nice.org.uk/ta NICE 2008 Contents
UNITED STATES PATENT AND TRADEMARK OFFICE BEFORE THE PATENT TRIAL AND APPEAL BOARD
 UNITED STATES PATENT AND TRADEMARK OFFICE BEFORE THE PATENT TRIAL AND APPEAL BOARD Boehringer Ingelheim International GmbH and Boehringer Ingelheim Pharmaceuticals, Inc. Petitioner, v. Biogen Idec, Inc.
UNITED STATES PATENT AND TRADEMARK OFFICE BEFORE THE PATENT TRIAL AND APPEAL BOARD Boehringer Ingelheim International GmbH and Boehringer Ingelheim Pharmaceuticals, Inc. Petitioner, v. Biogen Idec, Inc.
GLSG/OSHO Study Group. Supported by Deutsche Krebshilfe
 GLSG/OSHO Study Group Supported by Deutsche Krebshilfe GLSG/OSHO Study Group Study Concepts Follicular Lymphomas Mantel Cell Lymphomas Waldenstroem s Disease Key Steps in Improving Treatment for Follicular
GLSG/OSHO Study Group Supported by Deutsche Krebshilfe GLSG/OSHO Study Group Study Concepts Follicular Lymphomas Mantel Cell Lymphomas Waldenstroem s Disease Key Steps in Improving Treatment for Follicular
Hodgkin Lymphoma Disease Specific Biology and Treatment Options. John Kuruvilla
 Hodgkin Lymphoma Disease Specific Biology and Treatment Options John Kuruvilla My Disclaimer This is where I work Objectives Pathobiology what makes HL different Diagnosis Staging Treatment Philosophy
Hodgkin Lymphoma Disease Specific Biology and Treatment Options John Kuruvilla My Disclaimer This is where I work Objectives Pathobiology what makes HL different Diagnosis Staging Treatment Philosophy
Audience Response Question?
 Presenter Disclosure Information Session 4: 3:30 PM - 4:15 PM Non-Hodgkin s Lymphomas: Optimizing Therapeutic Choices for Initial Management Speaker: Arnold S. Freedman, MD The following relationships
Presenter Disclosure Information Session 4: 3:30 PM - 4:15 PM Non-Hodgkin s Lymphomas: Optimizing Therapeutic Choices for Initial Management Speaker: Arnold S. Freedman, MD The following relationships
The role of chemotherapy in follicular lymphomas Emanuele Zucca, M.D.
 The role of chemotherapy in follicular lymphomas Emanuele Zucca, M.D. Oncology Institute of Southern Switzerland (IOSI) Swiss Group for Clinical Cancer Research (SAKK) WHO grading of follicular lymphoma
The role of chemotherapy in follicular lymphomas Emanuele Zucca, M.D. Oncology Institute of Southern Switzerland (IOSI) Swiss Group for Clinical Cancer Research (SAKK) WHO grading of follicular lymphoma
Cancer Treatments Subcommittee of PTAC Meeting held 18 September 2015. (minutes for web publishing)
 Cancer Treatments Subcommittee of PTAC Meeting held 18 September 2015 (minutes for web publishing) Cancer Treatments Subcommittee minutes are published in accordance with the Terms of Reference for the
Cancer Treatments Subcommittee of PTAC Meeting held 18 September 2015 (minutes for web publishing) Cancer Treatments Subcommittee minutes are published in accordance with the Terms of Reference for the
Management of low grade glioma s: update on recent trials
 Management of low grade glioma s: update on recent trials M.J. van den Bent The Brain Tumor Center at Erasmus MC Cancer Center Rotterdam, the Netherlands Low grades Female, born 1976 1 st seizure 2005,
Management of low grade glioma s: update on recent trials M.J. van den Bent The Brain Tumor Center at Erasmus MC Cancer Center Rotterdam, the Netherlands Low grades Female, born 1976 1 st seizure 2005,
Supplementary Online Content
 Supplementary Online Content Huang H, Li X, Zhu J, et al. Entecavir vs lamivudine for prevention of hepatitis B virus reactivation among patients with untreated diffuse large B-cell lymphoma receiving
Supplementary Online Content Huang H, Li X, Zhu J, et al. Entecavir vs lamivudine for prevention of hepatitis B virus reactivation among patients with untreated diffuse large B-cell lymphoma receiving
Corporate Medical Policy
 Corporate Medical Policy Hematopoietic Stem-Cell Transplantation for CLL and SLL File Name: Origination: Last CAP Review: Next CAP Review: Last Review: hematopoietic_stem-cell_transplantation_for_cll_and_sll
Corporate Medical Policy Hematopoietic Stem-Cell Transplantation for CLL and SLL File Name: Origination: Last CAP Review: Next CAP Review: Last Review: hematopoietic_stem-cell_transplantation_for_cll_and_sll
Background. t 1/2 of 3.7 4.7 days allows once-daily dosing (1.5 mg) with consistent serum concentration 2,3 No interaction with CYP3A4 inhibitors 4
 Abstract No. 4501 Tivozanib versus sorafenib as initial targeted therapy for patients with advanced renal cell carcinoma: Results from a Phase III randomized, open-label, multicenter trial R. Motzer, D.
Abstract No. 4501 Tivozanib versus sorafenib as initial targeted therapy for patients with advanced renal cell carcinoma: Results from a Phase III randomized, open-label, multicenter trial R. Motzer, D.
In ELOQUENT-2, Empliciti was evaluated in patients who had received one to three prior
 - First and only immunostimulatory antibody approved in the European Union for multiple myeloma - Accelerated assessment and approval based on long-term data from ELOQUENT-2, which evaluated Empliciti
- First and only immunostimulatory antibody approved in the European Union for multiple myeloma - Accelerated assessment and approval based on long-term data from ELOQUENT-2, which evaluated Empliciti
SCIENTIFIC DISCUSSION
 London, 13 October 2005 Product name: PEGINTRON Procedure No. EMEA/H/C/280/II/54 SCIENTIFIC DISCUSSION 7 Westferry Circus, Canary Wharf, London E14 4HB, UK Tel. (44-20) 74 18 84 00 Fax (44-20) 74 18 86
London, 13 October 2005 Product name: PEGINTRON Procedure No. EMEA/H/C/280/II/54 SCIENTIFIC DISCUSSION 7 Westferry Circus, Canary Wharf, London E14 4HB, UK Tel. (44-20) 74 18 84 00 Fax (44-20) 74 18 86
Audience Response Question? Non-Hodgkin s Lymphomas: Optimizing Therapeutic Choices for Initial Management. Presenter Disclosure Information
 Welcome to Master Class for Oncologists Session 4: 10:00 AM - 10:45 AM Miami, FL December 18, 2009 Non-Hodgkin s Lymphomas: Optimizing Therapeutic Choices for Initial Management Speaker: Arnold S. Freedman,
Welcome to Master Class for Oncologists Session 4: 10:00 AM - 10:45 AM Miami, FL December 18, 2009 Non-Hodgkin s Lymphomas: Optimizing Therapeutic Choices for Initial Management Speaker: Arnold S. Freedman,
Guidance for Industry FDA Approval of New Cancer Treatment Uses for Marketed Drug and Biological Products
 Guidance for Industry FDA Approval of New Cancer Treatment Uses for Marketed Drug and Biological Products U.S. Department of Health and Human Services Food and Drug Administration Center for Drug Evaluation
Guidance for Industry FDA Approval of New Cancer Treatment Uses for Marketed Drug and Biological Products U.S. Department of Health and Human Services Food and Drug Administration Center for Drug Evaluation
Lymphomas after organ transplantation
 Produced 21.03.2011 Revision due 21.03.2011 Lymphomas after organ transplantation People who have undergone an organ transplant are more at risk of developing lymphoma known as post-transplant lymphoproliferative
Produced 21.03.2011 Revision due 21.03.2011 Lymphomas after organ transplantation People who have undergone an organ transplant are more at risk of developing lymphoma known as post-transplant lymphoproliferative
Update on Follicular Lymphoma. Brad Kahl, M.D.
 Update on Follicular Lymphoma Brad Kahl, M.D. Follicular Lymphoma: 25% of NHL Cases Other subtypes (9%) T and NK cell (12%) Burkitt (2.5%) Diffuse large B cell (DLBCL) (30%) Mantle cell (6%) Follicular
Update on Follicular Lymphoma Brad Kahl, M.D. Follicular Lymphoma: 25% of NHL Cases Other subtypes (9%) T and NK cell (12%) Burkitt (2.5%) Diffuse large B cell (DLBCL) (30%) Mantle cell (6%) Follicular
Two Retroperitoneal Low-Grade B-Cell Lymphoma Successfully Treated With a Combination of Chimeric Anti-CD20 Monoclonal Antibody and CHOP Chemotherapy
 Two Retroperitoneal Low-Grade B-Cell Lymphoma Successfully Treated With a Combination of Chimeric Anti-CD20 Monoclonal Antibody and CHOP Chemotherapy Yoichi Kitamura, MD Kazuhiko Hayashi, MD Kazumi Uchida,
Two Retroperitoneal Low-Grade B-Cell Lymphoma Successfully Treated With a Combination of Chimeric Anti-CD20 Monoclonal Antibody and CHOP Chemotherapy Yoichi Kitamura, MD Kazuhiko Hayashi, MD Kazumi Uchida,
Scottish Medicines Consortium
 Scottish Medicines Consortium pemetrexed 500mg infusion (Alimta ) No. (192/05) Eli Lilly 8 July 2005 The Scottish Medicines Consortium has completed its assessment of the above product and advises NHS
Scottish Medicines Consortium pemetrexed 500mg infusion (Alimta ) No. (192/05) Eli Lilly 8 July 2005 The Scottish Medicines Consortium has completed its assessment of the above product and advises NHS
This clinical study synopsis is provided in line with Boehringer Ingelheim s Policy on Transparency and Publication of Clinical Study Data.
 abcd Clinical Study for Public Disclosure This clinical study synopsis is provided in line with s Policy on Transparency and Publication of Clinical Study Data. The synopsis which is part of the clinical
abcd Clinical Study for Public Disclosure This clinical study synopsis is provided in line with s Policy on Transparency and Publication of Clinical Study Data. The synopsis which is part of the clinical
DARATUMUMAB, A CD38 MONOCLONAL ANTIBODY IN PATIENTS WITH MULTIPLE MYELOMA - DATA FROM A DOSE- ESCALATION PHASE I/II STUDY
 DARATUMUMAB, A CD38 MONOCLONAL ANTIBODY IN PATIENTS WITH MULTIPLE MYELOMA - DATA FROM A DOSE- ESCALATION PHASE I/II STUDY Torben Plesner, Henk Lokhorst, Peter Gimsing, Hareth Nahi, Steen Lisby, Paul Richardson
DARATUMUMAB, A CD38 MONOCLONAL ANTIBODY IN PATIENTS WITH MULTIPLE MYELOMA - DATA FROM A DOSE- ESCALATION PHASE I/II STUDY Torben Plesner, Henk Lokhorst, Peter Gimsing, Hareth Nahi, Steen Lisby, Paul Richardson
Bendamustine for the fourth-line treatment of multiple myeloma
 LONDON CANCER NEW DRUGS GROUP RAPID REVIEW Bendamustine for the fourth-line treatment of multiple myeloma Contents Summary 1 Background 2 Epidemiology 3 Cost 6 References 7 Summary There is no standard
LONDON CANCER NEW DRUGS GROUP RAPID REVIEW Bendamustine for the fourth-line treatment of multiple myeloma Contents Summary 1 Background 2 Epidemiology 3 Cost 6 References 7 Summary There is no standard
If several different trials are mentioned in one publication, the data of each should be extracted in a separate data extraction form.
 General Remarks This template of a data extraction form is intended to help you to start developing your own data extraction form, it certainly has to be adapted to your specific question. Delete unnecessary
General Remarks This template of a data extraction form is intended to help you to start developing your own data extraction form, it certainly has to be adapted to your specific question. Delete unnecessary
Clinical Trial Design. Sponsored by Center for Cancer Research National Cancer Institute
 Clinical Trial Design Sponsored by Center for Cancer Research National Cancer Institute Overview Clinical research is research conducted on human beings (or on material of human origin such as tissues,
Clinical Trial Design Sponsored by Center for Cancer Research National Cancer Institute Overview Clinical research is research conducted on human beings (or on material of human origin such as tissues,
Proceedings of the World Small Animal Veterinary Association Sydney, Australia 2007
 Proceedings of the World Small Animal Sydney, Australia 2007 Hosted by: Next WSAVA Congress Rescue Chemotherapy Protocols for Dogs with Lymphoma Kenneth M. Rassnick, DVM, DACVIM (Oncology) Cornell University
Proceedings of the World Small Animal Sydney, Australia 2007 Hosted by: Next WSAVA Congress Rescue Chemotherapy Protocols for Dogs with Lymphoma Kenneth M. Rassnick, DVM, DACVIM (Oncology) Cornell University
Study Design. Date: March 11, 2003 Reviewer: Jawahar Tiwari, Ph.D. Ellis Unger, M.D. Ghanshyam Gupta, Ph.D. Chief, Therapeutics Evaluation Branch
 BLA: STN 103471 Betaseron (Interferon β-1b) for the treatment of secondary progressive multiple sclerosis. Submission dated June 29, 1998. Chiron Corp. Date: March 11, 2003 Reviewer: Jawahar Tiwari, Ph.D.
BLA: STN 103471 Betaseron (Interferon β-1b) for the treatment of secondary progressive multiple sclerosis. Submission dated June 29, 1998. Chiron Corp. Date: March 11, 2003 Reviewer: Jawahar Tiwari, Ph.D.
Prior Authorization Guideline
 Prior Authorization Guideline Guideline: PS Inj - Velcade Therapeutic Class: Antineoplastic Agents Therapeutic Sub-Class: Antineoplastic Client: PS Inj Approval Date: 10/2/2004 Revision Date: 5/22/2007
Prior Authorization Guideline Guideline: PS Inj - Velcade Therapeutic Class: Antineoplastic Agents Therapeutic Sub-Class: Antineoplastic Client: PS Inj Approval Date: 10/2/2004 Revision Date: 5/22/2007
The Clinical Trials Process an educated patient s guide
 The Clinical Trials Process an educated patient s guide Gwen L. Nichols, MD Site Head, Oncology Roche TCRC, Translational and Clinical Research Center New York DISCLAIMER I am an employee of Hoffmann-
The Clinical Trials Process an educated patient s guide Gwen L. Nichols, MD Site Head, Oncology Roche TCRC, Translational and Clinical Research Center New York DISCLAIMER I am an employee of Hoffmann-
亞 東 紀 念 醫 院 Follicular Lymphoma 臨 床 指 引
 前 言 : 惡 性 淋 巴 瘤 ( 或 簡 稱 淋 巴 癌 ) 乃 由 體 內 淋 巴 系 統 包 括 淋 巴 細 胞 淋 巴 管 淋 巴 腺 及 一 些 淋 巴 器 官 或 組 織 如 脾 臟 胸 腺 及 扁 桃 腺 等 所 長 出 的 惡 性 腫 瘤 依 腫 瘤 病 理 組 織 型 態 的 不 同 可 分 為 何 杰 金 氏 淋 巴 瘤 (Hodgkin s disease) 與 非 何 杰 金
前 言 : 惡 性 淋 巴 瘤 ( 或 簡 稱 淋 巴 癌 ) 乃 由 體 內 淋 巴 系 統 包 括 淋 巴 細 胞 淋 巴 管 淋 巴 腺 及 一 些 淋 巴 器 官 或 組 織 如 脾 臟 胸 腺 及 扁 桃 腺 等 所 長 出 的 惡 性 腫 瘤 依 腫 瘤 病 理 組 織 型 態 的 不 同 可 分 為 何 杰 金 氏 淋 巴 瘤 (Hodgkin s disease) 與 非 何 杰 金
Cancer Treatments Subcommittee of PTAC Meeting held 2 March 2012. (minutes for web publishing)
 Cancer Treatments Subcommittee of PTAC Meeting held 2 March 2012 (minutes for web publishing) Cancer Treatments Subcommittee minutes are published in accordance with the Terms of Reference for the Pharmacology
Cancer Treatments Subcommittee of PTAC Meeting held 2 March 2012 (minutes for web publishing) Cancer Treatments Subcommittee minutes are published in accordance with the Terms of Reference for the Pharmacology
Rituximab in the Management of Follicular Lymphoma
 Hong Kong J Radiol. 2011;14(Suppl):S63-7 REVIEW ARTICLE Rituximab in the Management of Follicular Lymphoma YL Kwong Department of Medicine, Professorial Block, Queen Mary Hospital, Pokfulam Road, Hong
Hong Kong J Radiol. 2011;14(Suppl):S63-7 REVIEW ARTICLE Rituximab in the Management of Follicular Lymphoma YL Kwong Department of Medicine, Professorial Block, Queen Mary Hospital, Pokfulam Road, Hong
Acute Myeloid Leukemia
 Acute Myeloid Leukemia Upfront Therapy in Newly Diagnosed Elderly AML Patients: Is Decitabine (DAC) the new standard? Raoul Tibes, MD, PhD Senior Associate Consultant, Mayo Clinic Arizona Associate Director,
Acute Myeloid Leukemia Upfront Therapy in Newly Diagnosed Elderly AML Patients: Is Decitabine (DAC) the new standard? Raoul Tibes, MD, PhD Senior Associate Consultant, Mayo Clinic Arizona Associate Director,
Prior Authorization Guideline
 Prior Authorization Guideline Guideline: PS Inj - Alimta Therapeutic Class: Antineoplastic Agents Therapeutic Sub-Class: Antifolates Client: PS Inj Approval Date: 8/2/2004 Revision Date: 12/5/2006 I. BENEFIT
Prior Authorization Guideline Guideline: PS Inj - Alimta Therapeutic Class: Antineoplastic Agents Therapeutic Sub-Class: Antifolates Client: PS Inj Approval Date: 8/2/2004 Revision Date: 12/5/2006 I. BENEFIT
NATIONAL CANCER DRUG FUND PRIORITISATION SCORES
 NATIONAL CANCER DRUG FUND PRIORITISATION SCORES Drug Indication Regimen (where appropriate) BORTEZOMIB In combination with dexamethasone (VD), or with dexamethasone and thalidomide (VTD), is indicated
NATIONAL CANCER DRUG FUND PRIORITISATION SCORES Drug Indication Regimen (where appropriate) BORTEZOMIB In combination with dexamethasone (VD), or with dexamethasone and thalidomide (VTD), is indicated
Long Term Low Dose Maintenance Chemotherapy in the Treatment of Acute Myeloid Leukemia
 Long Term Low Dose Chemotherapy in the Treatment of Acute Myeloid Leukemia Murat TOMBULO LU*, Seçkin ÇA IRGAN* * Department of Hematology, Faculty of Medicine, Ege University, zmir, TURKEY ABSTRACT In
Long Term Low Dose Chemotherapy in the Treatment of Acute Myeloid Leukemia Murat TOMBULO LU*, Seçkin ÇA IRGAN* * Department of Hematology, Faculty of Medicine, Ege University, zmir, TURKEY ABSTRACT In
Corporate Medical Policy
 Corporate Medical Policy File Name: Origination: Last CAP Review: Next CAP Review: Last Review: hematopoietic_stem-cell_transplantation_for_epithelial_ovarian_cancer 2/2001 11/2015 11/2016 11/2015 Description
Corporate Medical Policy File Name: Origination: Last CAP Review: Next CAP Review: Last Review: hematopoietic_stem-cell_transplantation_for_epithelial_ovarian_cancer 2/2001 11/2015 11/2016 11/2015 Description
The NCPE has issued a recommendation regarding the use of pertuzumab for this indication. The NCPE does not recommend reimbursement of pertuzumab.
 Cost Effectiveness of Pertuzumab (Perjeta ) in Combination with Trastuzumab and Docetaxel in Adults with HER2-Positive Metastatic or Locally Recurrent Unresectable Breast Cancer Who Have Not Received Previous
Cost Effectiveness of Pertuzumab (Perjeta ) in Combination with Trastuzumab and Docetaxel in Adults with HER2-Positive Metastatic or Locally Recurrent Unresectable Breast Cancer Who Have Not Received Previous
Advances In Chemotherapy For Hormone Refractory Prostate Cancer. TAX 327 study results & SWOG 99-16 study results presented at ASCO 2004
 Ronald de Wit Rotterdam Cancer Institute The Netherlands Advances In Chemotherapy For Hormone Refractory Prostate Cancer TAX 327 study results & SWOG 99-16 study results presented at Slide 1 Prostate Cancer
Ronald de Wit Rotterdam Cancer Institute The Netherlands Advances In Chemotherapy For Hormone Refractory Prostate Cancer TAX 327 study results & SWOG 99-16 study results presented at Slide 1 Prostate Cancer
Update in Hematology Oncology Targeted Therapies. Mark Holguin
 Update in Hematology Oncology Targeted Therapies Mark Holguin 25 years ago Why I chose oncology People How to help people with possibly the most difficult thing they may have to deal with Science Turning
Update in Hematology Oncology Targeted Therapies Mark Holguin 25 years ago Why I chose oncology People How to help people with possibly the most difficult thing they may have to deal with Science Turning
6/3/2013. Follicular and Other Slow Growing Lymphomas. Stephen Ansell, MD, PhD Mayo Clinic
 Follicular and Other Slow Growing Lymphomas Stephen Ansell, MD, PhD Mayo Clinic 1 Learning Objectives Start with an overview of Follicular and other slow growing lymphomas Discuss current and emerging
Follicular and Other Slow Growing Lymphomas Stephen Ansell, MD, PhD Mayo Clinic 1 Learning Objectives Start with an overview of Follicular and other slow growing lymphomas Discuss current and emerging
DIFFUSE LARGE B-CELL LYMPHOMA
DIFFUSE LARGE B-CELL LYMPHOMA Executive Summary Diffuse large B-cell lymphoma (DLBCL) is the most common subtype of non-hodgkin lymphoma (NHL), constituting up to 40% of all cases globally.[1] This subtype
DIFFUSE LARGE B-CELL LYMPHOMA Executive Summary Diffuse large B-cell lymphoma (DLBCL) is the most common subtype of non-hodgkin lymphoma (NHL), constituting up to 40% of all cases globally.[1] This subtype
Scottish Medicines Consortium
 Scottish Medicines Consortium peginterferon alfa-2a, 135 microgram/ml and 180 microgram/ml pre-filled injections of solution for subcutaneous injection (Pegasys ) No. (561/09) Roche Products Limited 10
Scottish Medicines Consortium peginterferon alfa-2a, 135 microgram/ml and 180 microgram/ml pre-filled injections of solution for subcutaneous injection (Pegasys ) No. (561/09) Roche Products Limited 10
National MS Society Information Sourcebook www.nationalmssociety.org/sourcebook
 National MS Society Information Sourcebook www.nationalmssociety.org/sourcebook Chemotherapy The literal meaning of the term chemotherapy is to treat with a chemical agent, but the term generally refers
National MS Society Information Sourcebook www.nationalmssociety.org/sourcebook Chemotherapy The literal meaning of the term chemotherapy is to treat with a chemical agent, but the term generally refers
Clinical trials. Patient information. For anyone affected by blood cancer. bloodwise.org.uk
 Clinical trials For anyone affected by blood cancer bloodwise.org.uk Patient information A note about this booklet This booklet has been produced by Bloodwise, the new name for Leukaemia & Lymphoma Research.
Clinical trials For anyone affected by blood cancer bloodwise.org.uk Patient information A note about this booklet This booklet has been produced by Bloodwise, the new name for Leukaemia & Lymphoma Research.
cancer cancer Hessamfar-Bonarek M et al. Int. J. Epidemiol. 2010;39:135-146
 Hematopoietic Stem Cell Transplant in HIV- related lymphoma Song Zhao, MD PhD Hematology-Oncology Program University of Washington/FHCRC Underlying Causes of Death in HIV-infected Adults 2000 2005 cancer
Hematopoietic Stem Cell Transplant in HIV- related lymphoma Song Zhao, MD PhD Hematology-Oncology Program University of Washington/FHCRC Underlying Causes of Death in HIV-infected Adults 2000 2005 cancer
Henk Lokhorst, Torben Plesner, Peter Gimsing, Hareth Nahi, Steen Lisby, Paul Richardson
 DRTUMUMB, a CD38 Monoclonal ntibody Study in dvanced Multiple Myeloma an Open-Label, Dose Escalation Followed by Open-Label Extension in a Single-rm Phase I/II Study bstract #S576 Henk Lokhorst, Torben
DRTUMUMB, a CD38 Monoclonal ntibody Study in dvanced Multiple Myeloma an Open-Label, Dose Escalation Followed by Open-Label Extension in a Single-rm Phase I/II Study bstract #S576 Henk Lokhorst, Torben
Adoption by CHMP for release for consultation November 2010. End of consultation (deadline for comments) 31 March 2011
 1 2 3 November 2010 EMA/759784/2010 Committee for Medicinal Products for Human Use 4 5 6 7 Reflection paper on the need for active control in therapeutic areas where use of placebo is deemed ethical and
1 2 3 November 2010 EMA/759784/2010 Committee for Medicinal Products for Human Use 4 5 6 7 Reflection paper on the need for active control in therapeutic areas where use of placebo is deemed ethical and
Michael Crump MD. Lymphoma Site Leader Princess Margaret Hospital University of Toronto
 Evolution of Lymphoma Therapy: What can we expect for the rest of the millenium decade? Michael Crump MD Lymphoma Site Leader Princess Margaret Hospital University of Toronto disclaimers Served on advisory
Evolution of Lymphoma Therapy: What can we expect for the rest of the millenium decade? Michael Crump MD Lymphoma Site Leader Princess Margaret Hospital University of Toronto disclaimers Served on advisory
Cure versus control: Which is the best strategy?
 Cure versus control: Which is the best strategy? Barcelona 8-9-2012 Mario Boccadoro DIVISIONE UNIVERSITARIA DI EMATOLOGIA AZIENDA OSPEDALIERA SAN GIOVANNI TORINO, ITALY MULTIPLE MYELOMA Cure versus control
Cure versus control: Which is the best strategy? Barcelona 8-9-2012 Mario Boccadoro DIVISIONE UNIVERSITARIA DI EMATOLOGIA AZIENDA OSPEDALIERA SAN GIOVANNI TORINO, ITALY MULTIPLE MYELOMA Cure versus control
DE Tsai 1, HCF Moore 1, CL Hardy 2, DL Porter 1, EY Loh 1, DJ Vaughn 1, S Luger 1, SJ Schuster 1 and EA Stadtmauer 1
 Bone Marrow Transplantation, (1999) 24, 521 526 1999 Stockton Press All rights reserved 0268 3369/99 $15.00 http://www.stockton-press.co.uk/bmt Rituximab (anti-cd20 monoclonal antibody) therapy for progressive
Bone Marrow Transplantation, (1999) 24, 521 526 1999 Stockton Press All rights reserved 0268 3369/99 $15.00 http://www.stockton-press.co.uk/bmt Rituximab (anti-cd20 monoclonal antibody) therapy for progressive
J Clin Oncol 23:8447-8452. 2005 by American Society of Clinical Oncology INTRODUCTION
 VOLUME 23 NUMBER 33 NOVEMBER 20 2005 JOURNAL OF CLINICAL ONCOLOGY O R I G I N A L R E P O R T New Treatment Options Have Changed the Survival of Patients With Follicular Lymphoma Richard I. Fisher, Michael
VOLUME 23 NUMBER 33 NOVEMBER 20 2005 JOURNAL OF CLINICAL ONCOLOGY O R I G I N A L R E P O R T New Treatment Options Have Changed the Survival of Patients With Follicular Lymphoma Richard I. Fisher, Michael
SYNOPSIS. Risperidone: Clinical Study Report CR003274
 SYNOPSIS Protocol No: CR003274 Title of Study: An Open-Label, Long-Term Trial of Risperidone Long-Acting Microspheres in the Treatment of Subjects Diagnosed with Schizophrenia Coordinating Investigator:
SYNOPSIS Protocol No: CR003274 Title of Study: An Open-Label, Long-Term Trial of Risperidone Long-Acting Microspheres in the Treatment of Subjects Diagnosed with Schizophrenia Coordinating Investigator:
Hematopoietic Stem Cell Transplantation. Imad A. Tabbara, M.D. Professor of Medicine
 Hematopoietic Stem Cell Transplantation Imad A. Tabbara, M.D. Professor of Medicine Hematopoietic Stem Cells Harvested from blood, bone marrow, umbilical cord blood Positive selection of CD34 (+) cells
Hematopoietic Stem Cell Transplantation Imad A. Tabbara, M.D. Professor of Medicine Hematopoietic Stem Cells Harvested from blood, bone marrow, umbilical cord blood Positive selection of CD34 (+) cells
Chemoimmunotherapy resistant follicular lymphoma A single institutional study
 Cancer Research Journal 2014; 2(5): 93-97 Published online September 30, 2014 (http://www.sciencepublishinggroup.com/j/crj) doi: 10.11648/j.crj.20140205.13 ISSN: 2330-8192 (Print); ISSN: 2330-8214 (Online)
Cancer Research Journal 2014; 2(5): 93-97 Published online September 30, 2014 (http://www.sciencepublishinggroup.com/j/crj) doi: 10.11648/j.crj.20140205.13 ISSN: 2330-8192 (Print); ISSN: 2330-8214 (Online)
An overview of CLL care and treatment. Dr Dean Smith Haematology Consultant City Hospital Nottingham
 An overview of CLL care and treatment Dr Dean Smith Haematology Consultant City Hospital Nottingham What is CLL? CLL (Chronic Lymphocytic Leukaemia) is a type of cancer in which the bone marrow makes too
An overview of CLL care and treatment Dr Dean Smith Haematology Consultant City Hospital Nottingham What is CLL? CLL (Chronic Lymphocytic Leukaemia) is a type of cancer in which the bone marrow makes too
Estimated New Cases of Leukemia, Lymphoma, Myeloma 2014
 ABOUT BLOOD CANCERS Leukemia, Hodgkin lymphoma (HL), non-hodgkin lymphoma (NHL), myeloma, myelodysplastic syndromes (MDS) and myeloproliferative neoplasms (MPNs) are types of cancer that can affect the
ABOUT BLOOD CANCERS Leukemia, Hodgkin lymphoma (HL), non-hodgkin lymphoma (NHL), myeloma, myelodysplastic syndromes (MDS) and myeloproliferative neoplasms (MPNs) are types of cancer that can affect the
Maintenance therapy in in Metastatic NSCLC. Dr Amit Joshi Associate Professor Dept. Of Medical Oncology Tata Memorial Centre Mumbai
 Maintenance therapy in in Metastatic NSCLC Dr Amit Joshi Associate Professor Dept. Of Medical Oncology Tata Memorial Centre Mumbai Definition of Maintenance therapy The U.S. National Cancer Institute s
Maintenance therapy in in Metastatic NSCLC Dr Amit Joshi Associate Professor Dept. Of Medical Oncology Tata Memorial Centre Mumbai Definition of Maintenance therapy The U.S. National Cancer Institute s

 Understanding Clinical Trials HR =.6 (CI :.51.7) p
Understanding Clinical Trials HR =.6 (CI :.51.7) p